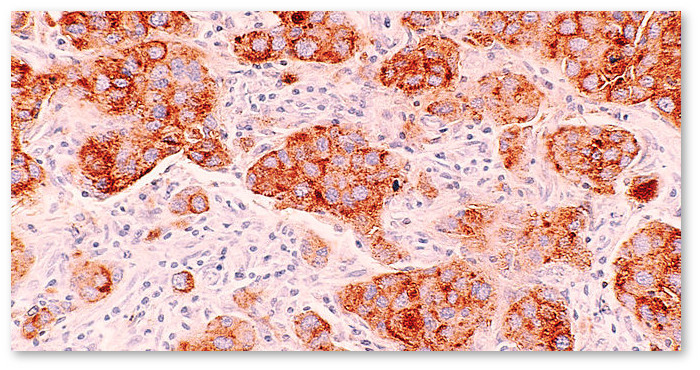
breast-cancer-marijuana-06-10-720x340

На протяжении почти десяти лет группа ученых из Медицинского центра Калифорния Пасифик изучала противораковый потенциал компонентов марихуаны.
Активные вещества марихуаны (каннабиноиды), в первую очередь ТГК (тетрагидроканнабинол) и КБД (каннабидиол), продемонстрировали способность останавливать рост и распространение опухолей при различных видах рака.
Последние открытия группы, опубликованные онлайн в Британском журнале фармакологии, указывают на то, что каннабиноиды являются многообещающим средством в борьбе с раком молочной железы.
"Мы установили, что КБД эффективен в подавлении метастатического прогрессирования, обеспечивая большую продолжительность жизни в различных доклинических моделях рака молочной железы", - пишет д-р Шон МакАлистер, руководитель научной группы.
В одной из моделей тестирования на мышах каннабидиол обеспечил снижение метастаз рака молочной железы на 75%. Хотя ТГК и не тестировался, ученые отмечают, что предыдущие исследования продемонстрировали его противоопухолевое действие "против различных форм агрессивного рака".
Однако исследование научной группы, похоже, указывает на то, что ни одно из вышеупомянутых соединений в отдельности не является наиболее эффективным средством.<
В поисках более действенного соединения исследователи провели эксперименты с синтетическим каннабиноидом O-1663, который проявил себя как "значительно более действенный и эффективный, чем КБД".
Интересно, что O-1663, по-видимому, активирует те же самые противораковые сигнальные пути, что и ТГК и КБД вместе взятые.
"В согласии с этой гипотезой, одновременное применение КБД и ТГК привело к увеличенной антиметастатической активности, сравнимой по эффективности с O-1663", - пишут д-р МакАлистер и его команда.
Установлено, что противораковые эффекты ТГК возникают в результате воздействия на сигнальные пути, называемые каннабиноидными рецепторами (CB1 и CB2). Эти рецепторы, хотя и присутствуют в различных клетках по всему организму, встречаются в раковых тканях в ненормально высокой концентрации.
Активация рецепторов CB1 и CB2 запускает ряд механизмов, приводящих к гибели раковых клеток, но сохраняющих здоровые клетки нетронутыми.
Каннабидиол, однако не воздействует непосредственно на каннабиноидные рецепторы. Скорее противораковые эффекты КБД вытекают из его способности воздействовать на ген ID1 — известный фактор в образовании метастаз при многих формах рака, в том числе рака молочной железы.
Хотя O-1663, по-видимому, является более многообещающим вариантом в лечении рака молочной железы, чем ТГК или КБД по отдельности, авторы исследования отмечают, что у натуральных соединений, добытых из растения, есть и другие полезные свойства.
"ТГК и КБД продемонстрировали противовоспалительное, обезболивающее и нейропротекторное действие", - поясняют они. Медицинская марихуана в различных формах также может использоваться для снижения таких симптомов как потеря аппетита и тошнота.
В заключение исследователи написали, что требуются дальнейшие исследования тех механизмов, которые лежат в основе более широкого лечебного действия ТГК и КБД, а также следует выяснить, не проявит ли и O-1663 те же свойства.




Комментарии (0)